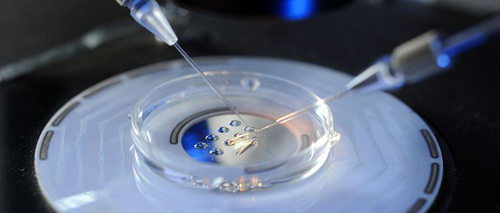

看网上说国内可以冻卵,但是有一定条件 ,我今年32岁,没有朋友,未婚,想保证未来孩子的质量想做冻卵手术,未婚没有结婚证国内哪家医院可以冻卵?
国内冻卵暂时未对单身女性开放,根据原卫生部2003年颁布的《人类辅助生殖技术规范》规定单身女性不能使用人类辅助生殖技术,所以单身女性不能在中国大陆“冻卵”,即便是已婚女性,她们如果想要冷冻及储存卵子的话,都有不少限制。国内冻卵适合人群有以下三类:
1、卵巢早衰的女性,因自身免疫疾病、感染、肿瘤等因素导致卵巢早衰的女性需要对卵巢组织进行冷冻,先治疗身体疾病再行冻卵;
2、卵巢破坏的女性,因肿瘤进行全身较大剂量放化疗前,或者严重的、复发的卵巢囊肿进行多次外科治疗导致卵巢破坏的女性,可以先冷冻卵子再接受化疗;
3、因各种原因暂不能生育的女性,对于因各种原因暂不能生育的女性,可在法律允许的范围内进行卵巢组织冷冻或卵子冷冻。

国内冻卵适合人群
听说现在国外可以未婚冻卵,很多明星也有说在国外冻卵了,我现在33了,还没有结婚,也想冻卵,请问国内可以冻卵吗?国内冻卵的条件有哪些?
虽然国外是允许未婚冻卵,但是国内未婚女性不能冻卵,就算是已经结婚的女性,也不一定能满足冻卵条件,国内已婚女性要满足条件:
1、准备好准生证、身份证、结婚证这些手续;
2、本身生育功能出现问题的已婚女性。
国内女性冻卵条件
看到电视节目上,很多明显有在国外冻卵,还有新闻说上海、深圳、北京等发达地区有可以冻卵的医院,而且冻卵费用也不高,我未婚,想冻卵,冻卵的流程是怎么样的呢?
因为年龄增加卵子库存量会逐渐减少,卵子染色体异常率也越来越高,所以越来越多女性择冻卵,冻卵流程其实比较简单,具体如下:
1、登记、体检;
2、打排卵针;
3、取卵,卵泡液送至实验室;
4、提取出卵母细胞;
5、卵子脱水6.迅速放入有液氮的专用容器中;
6、将卵子转入液氮罐中保存;
7、使用时利用试剂进行复苏。
